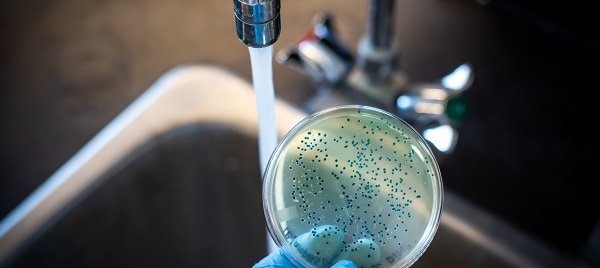

Últimas notícias
01/09/2020 - Ministério da Saúde traça panorama da febre tifoide no Brasil
Neste mês de agosto, a Secretaria de Vigilância em Saúde do Ministério da Saúde publicou, em seu Boletim Epidemiológico 34, um estudo descritivo do perfil epidemiológico da febre tifoide no Brasil entre 2010 e 2019. No período, foram 1.127 casos – 792 deles na região Norte, que concentrou 70,3% dos episódios.
Todo o País apresentou notificações confirmadas. No Nordeste, foram 206 (18,3%) e no Sudeste 100 (8,9%). Os números foram menores no Sul e no Centro-Oeste, que tiveram, respectivamente, 15 (1,3%) e 14 (1,2%) casos.
Os estados do Pará, Amapá e Amazonas foram os que mais confirmaram casos da doença, enquanto Roraima, Goiás e Mato Grosso do Sul não tiveram nenhum. Como 74,4% dos casos foram autóctones no município de residência dos doentes, esses dados, segundo o Ministério, podem nortear a doação de estratégias locais de prevenção e controle da febre.
O boletim também destaca que 58,2% dos doentes eram do sexo masculino, “o que pode ser atribuído aos hábitos de vida desses indivíduos, menos preocupados com as condições de higiene dos alimentos e dos ambientes em que foram preparados”.
E os jovens foram os mais afetados. Quase 29% dos casos ocorreram entre pessoas de 20 a 34 anos. Se a faixa for estendida até os 49, o número sobe para mais de 47%. As crianças de 5 a 9 anos também representaram faixa importante, concentrando 12,5% dos casos.
No período analisado, a incidência média anual da doença no Brasil foi de 0,05 casos por 100 mil habitantes. Para efeito de comparação, o valor é inferior ao observado no Marrocos, entre 2011 e 2017, que teve 0,7 casos por 100 mil hab., ou na França, em 2016, que teve 0,65 casos por 100 mil hab.
Febre tifoide
Esta é uma doença bacteriana aguda, de distribuição mundial, associada a baixos níveis socioeconômicos. É causada pela Salmonella enterica e caracterizada por febre alta, cefaleia, diarreia ou constipação e dor abdominal, podendo evoluir para perfurações intestinais, complicações em órgãos e óbitos.
Os humanos são os únicos reservatórios da doença, que é transmitida de forma direta (contato com o portador, por exemplo) e indireta (relacionada à água e/ou ao alimento contaminado). A doença pode ser tratada com antibióticos, embora tenha se tornado mais comum cepas de Salmonella resistentes a diferentes tipos de antimicrobianos.
Fatores de risco incluem a precariedade do saneamento básico, a insuficiência de boas práticas desde a cadeia produtiva dos alimentos até o consumo final, a carência de hábitos de higiene pessoal adequados e a ingestão de frutas e vegetais crus.
A Organização Mundial de Saúde estima que, ao ano, 11 a 20 milhões de pessoas adoecem no mundo por febre tifoide, resultando em cerca de 150 mil mortes. A presença da doença é mais notada na América Latina, na Ásia e na África.





















 Educação Médica
Educação Médica  Valorização de Honorários
Valorização de Honorários  Financiamento da saúde
Financiamento da saúde  Carreira de Estado
Carreira de Estado  Redução de impostos
Redução de impostos  Pesquisas Datafolha
Pesquisas Datafolha